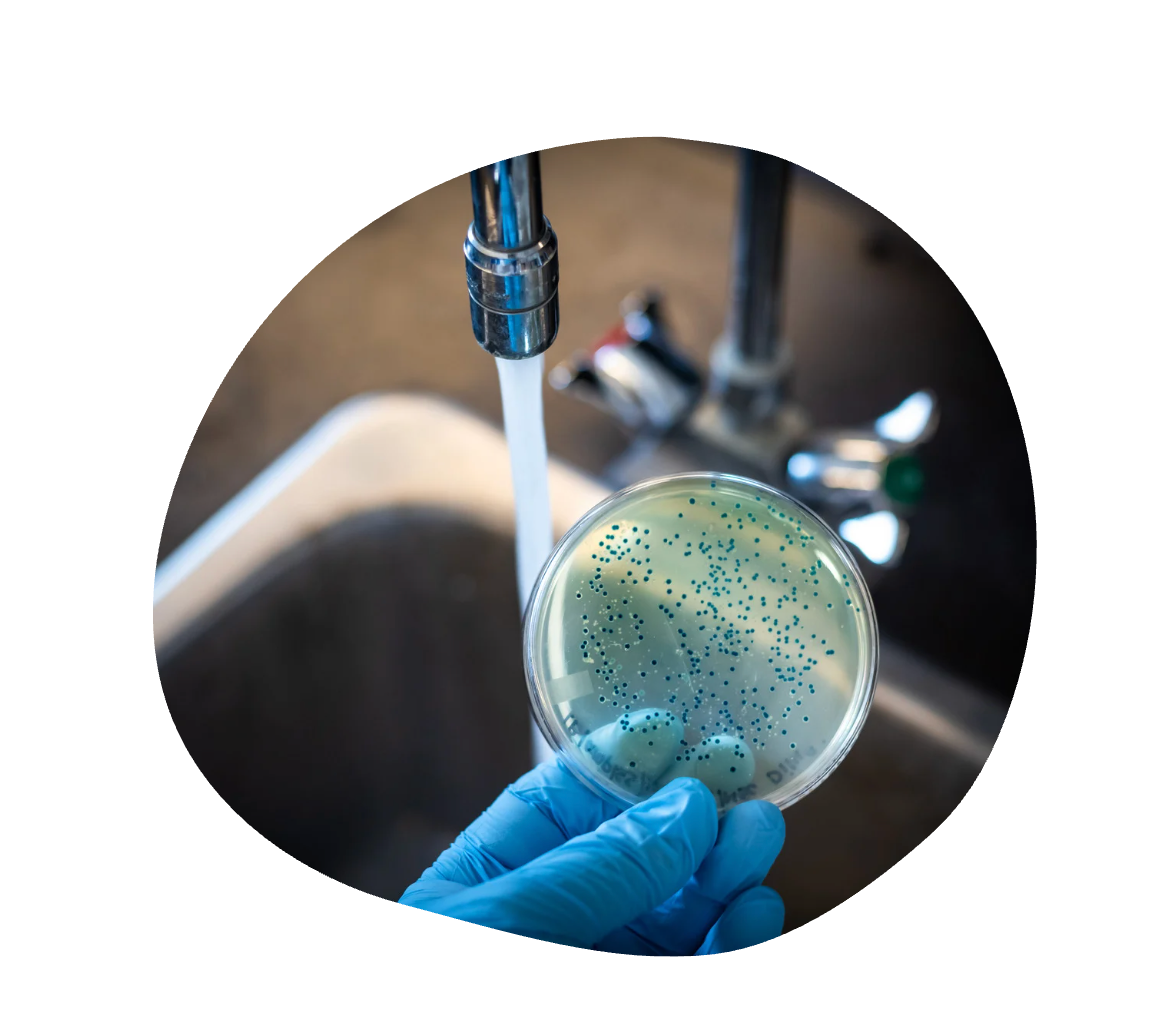

Filtre sous évier PuriQuel
Filtre sous évier PuriQuel
🚫 Fini les packs d’eau à porter
💧 Une eau sans odeur ni arrière-goût
🛠️ Installation rapide en 10 minutes

Le Filtre De Remplacement
Impossible de charger la disponibilité du service de retrait

Filtre sous évier PuriQuel

Le service de communication et de conseil a été parfait avec des réponses instantanées. Je recommande.
la filtration fonctionne très bien.
check_box
Garantie 100 % satisfait ou remboursé
Garantie 100 % satisfait ou remboursé
Nous sommes convaincus de la qualité de notre filtre Puriquel®.
C’est pourquoi vous bénéficiez d’une garantie 30 jours satisfait ou remboursé.
Vous essayez. Vous testez. Vous décidez.
Si, pour n’importe quelle raison, vous n’êtes pas pleinement satisfait(e), il vous suffit de nous contacter dans les 30 jours suivant la réception, et nous vous remboursons intégralement.
Achetez en toute confiance.
Votre satisfaction est notre priorité.
check_box
Expédition
Expédition
Une fois votre commande validée, elle est préparée et expédiée sous 24 à 48 heures ouvrées.
Le délai moyen de livraison est compris entre 6 et 10 jours.
Veuillez noter que ce délai peut être légèrement rallongé en période de forte affluence (fêtes, soldes, etc.)
check_box
FAQ Fréquentes
FAQ Fréquentes
Quels types de filtration propose Puriquel ?
Le filtre intègre 5 étapes de purification dans une seule cartouche :
- ➤ Filtre les particules, sable, rouille, sédiments
- ➤ Élimine le chlore, les odeurs, et les goûts désagréables
- ➤ Inhibe les bactéries, prolonge la durée de vie du filtre, et supprime les métaux lourds (plomb, mercure…)
- ➤ Réduction efficace du fluor pour une eau plus saine
- ➤ Supprime bactéries, micro-organismes, microplastiques, tout en préservant les minéraux essentiels
Est-ce que le filtre Puriquel supprime les PFAS et microplastiques ?
Oui. Grâce à la finesse de 0,01 micron et aux couches filtrantes (UF + KDF + charbon actif), il permet de réduire considérablement les PFAS (polluants persistants) et filtrer les microplastiques invisibles à l’œil nu.
Quelle est la durée de vie du filtre ?
Le filtre dure en moyenne 12 mois, selon votre consommation (jusqu’à 19 000 gallons) Il est recommandé pour un usage domestique intensif.
Est-ce facile à installer ?
Oui. L’installation se fait en moins de 10 minutes, sans besoin d’outils spécifiques. Tout est fourni avec le produit.
Réduit-il le calcaire ?
Il réduit les particules de calcaire, mais ce n’est pas un adoucisseur. Il n’enlève pas la dureté de l’eau, mais améliore la clarté et le goût.
Convient-il aux appartements ?
Oui, parfaitement. Il se glisse discrètement sous l’évier, ne fait pas de bruit, et ne demande aucune modification permanente.
Quelle différence avec un osmoseur ?
Contrairement à l’osmose inverse, le filtre Puriquel :
– Ne rejette pas d’eau
– Ne retire pas les minéraux essentiels
– Ne nécessite pas d’électricité
C’est une solution plus simple, plus rapide, et plus naturelle pour purifier l’eau du robinet.
Remplace-t-il l’eau en bouteille ?
Oui. Grâce à sa technologie, l’eau filtrée est claire, saine et agréable à boire, tous les jours.
👉 Fini les packs d’eau à porter. Bonjour à l’eau propre au robinet.
Que contient le kit Puriquel ?



Le filtre
PuriQuel
Sous évier 100 fois plus performant qu’une carafe classique.
il élimine bactéries, métaux lourds, fluor, microplastiques… tout en préservant les bons minéraux.
Résultat ?
Une eau saine, au goût pur, directement au robinet et ça, sans électricité, sans bouteille, sans effort.
L’Eau
du Robinet
Pas aussi Pure Qu’on le Pense. Derrière son apparence claire, l’eau du robinet contient du chlore, des métaux lourds, des résidus de pesticides et des microplastiques.
Les canalisations anciennes et les traitements chimiques dégradent sa qualité, altèrent son goût… et posent un vrai risque pour la santé.
Avec Puriquel, transformez votre robinet en source d’eau pure, saine et agréable à boire.

L’Eau
en Bouteille
Une Fausse Bonne Idée. On croit souvent que l’eau en bouteille est plus saine… mais 98 % d’entre elles contiennent des microplastiques.
Ces particules se retrouvent dans notre sang, s’accrochent aux globules rouges et limitent le transport d’oxygène.
Pire encore, on en a détecté dans le placenta de femmes enceintes, posant un vrai risque pour la santé des générations futures.
Et au-delà de la santé, c’est aussi un coût élevé et une pollution plastique massive.
Installer Votre Filtre en 5 étapes Simples
-

1 Opération coupure d’eau!
Avant de jouer au plombier, assurez-vous de couper l’arrivée d’eau. Félicitations, vous venez de réaliser la partie la plus difficile !
-
2 Le bal des raccords
Prenez les deux raccords fournis et connectez-les au filtre. Imaginez que vous les présentez à leur futur meilleur ami, le filtre !
-

3 Mission débranchage
Déconnectez le tuyau de l'eau froide sous votre évier. Informez-le que ses soirées "porte ouverte" sont officiellement terminées
-

4 Branchement simple !
Connectez le raccord côté inlet à votre arrivée d’eau. Puis, connectez le raccord côté outlet à votre évier. C’est comme mettre vos baskets à l'endroit
-

5 L’heure de vérité
Ouvrez l’eau et laissez-la couler quelques minutes. C’est comme rincer votre nouvelle cafetière avant le premier usage.
-

Et voilà, c'est fini !
Félicitation vous avez installé avec succès votre filtre. Vous pouvez maintenant profiter d'une eau plus propre et plus claire directement de votre robinet.
Ce que disent les études
Ce qu’on boit chaque jour cache des dangers invisibles… et les chiffres sont choquants.
98%
des eaux en bouteille contiennent des microplastiques Ces particules se retrouvent dans le sang et même dans le placenta. (Source : SUNY Fredonia / WHO)
20%
des réseaux d’eau délivrent une eau non conforme à au moins un critère sanitaire
Pesticides, nitrates, résidus médicamenteux ou métaux lourds.
(Source : UFC-Que Choisir / OMS)
100%
1 million de bouteilles plastiques sont jetées chaque minute dans le monde
Et moins de 10 % sont réellement recyclées. (Source : National Geographic)
Ils en parlent mieux que nous
-
Vraiment un service super, le site est super fiable.
On est toujours en contact avec une personne qui nous aide si besoin.
Vraiment je conseille.
Le filtre me paraît d'une grande qualité.Jean
-
je l'ai acheté également pour arroser mes plantes. J'ai remarqué une amelioration avec le filtre, donc je suppose qu'il fait son travail. 🙂
Mael
-
Enfin je vais pouvoir boire de l’eau du robinet 🚰 plus de bouteilles plastiques
Súper contente 😀
Merci 🙏Ana
-
Installation facile, la qualité de l'eau est considérablement améliorée. Produit avec tous les accessoires nécessaires à l'installation. Excellent 👍
David
-
Je l'utilise depuis 3 mois maintenant et je suis très satisfaite des performances, du goût et de la qualité dans son ensemble.
Julie
-
Tres facile à installer, eau douce ,sans goût désagréable
Patrick
-
Assez facile à installer, bien fait. Filtre bien l'eau.
Geraldine
-
top, installation simple et rapide
Fred
-
Eau ultra calcaire. Je dois changer le filtre au bout de 3 mois.
Viridiana
-
parfait...
Paquin
-
ah fini le l'odeur et le gout désagréable
Alphonse
-
L'installation du filtre a pris moins de 10 minutes! L'eau est désormais totalement neutre en goût, ce que mes plantes et moi adorons.
George


















